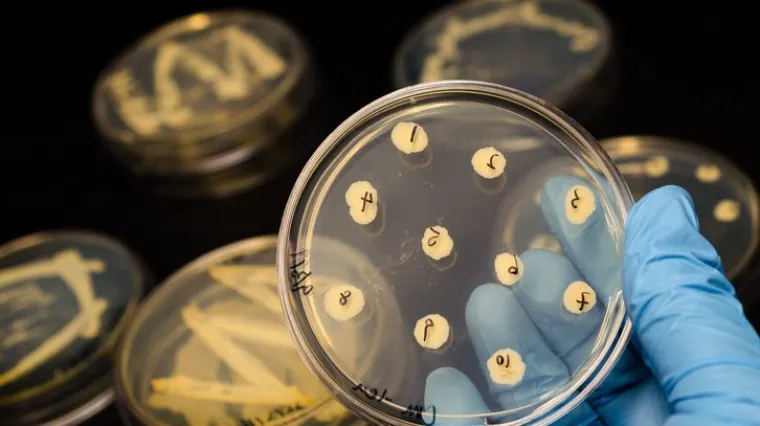
Šire se bolnicama, u liječenju ne pomaže ni jedan poznati antibiotik na svijetu

Šire se bolnicama, u liječenju ne pomaže ni jedan poznati antibiotik na svijetu
Otkrivena superbakterija koja je otporna na sve poznate antibiotike
Superbakterija otporna na sve poznate antibiotike širi se bolnicama diljem svijeta, upozoravaju australski znanstvenici.
Znanstvenici sa sveučilišta u Melbourneu otkrili su tri vrste otpornih bakterija u uzorcima iz deset zemalja, uključujući sojeve u Europi koji su otporni na sve lijekove trenutačno raspoložive na tržištu.
"Počeli smo u Australiji, ali smo proširili istraživanje i otkrili je u mnogim zemljama i u brojnim ustanovama diljem svijeta", kaže Joseph Howden, voditelj mikrobiološkog laboratorija sveučilišta.
Bakterija znana kao Staphylococcus epidermidis povezana je s poznatijom i smrtonosnijom MRSA-om.
Nalazi se na ljudskoj koži i najčešće se inficiraju starije osobe i osobe s kateterom ili umjetnim zglobovima
Može se prirodno pronaći na ljudskoj koži, a najčešće se njome inficiraju starije osobe ili pacijenti s protetskim implantatima poput katetera ili umjetnih zglobova.
"Može biti smrtonosna, ali obično u pacijenata koji su već teško bolesni ili su na bolničkom liječenju. Teško ju je pobijediti i infekcije mogu biti teške", napominje Howden.
Njegov tim proučavao je stotine uzoraka S. epidermisa iz 78 svjetskih bolnica i otkrio sojeve koji su s malim izmjenama u svojoj DNK postali otporni na dva najčešća antibiotika kojima se liječe bolničke infekcije.
"Ta dva antibiotika nisu slična sastava i ne biste očekivali da će samo jedna mutacija poništiti djelovanje obaju", dodala je znanstvenica Jean Lee, suautorica istraživanja.
Brzo širenje superbakterija zbog pretjerane upotrebe antibiotika
Stručnjaci smatraju da se superbakterija brzo širi zbog pretjerane upotrebe antibiotika na odjelima za intenzivnu skrb, gdje su pacijenti najbolesniji pa se i najjači lijekovi propisuju rutinski.
Svjetska zdravstvena organizacija već dugo upozorava da prekomjerna upotreba antibiotika potiče razvoj otpornih i ubojitih sojeva bakterija.
Howden je kazao da njegova studija, objavljena u časopisu Nature Microbiology, pokazuje potrebu za boljim razumijevanjem načina kako se šire zaraze i koje bi bakterije bolnice trebale "ciljati".
"S obzirom na sve bakterije u bolnicama, nema nikakve sumnje da je otpornost na antibiotike jedna od najvećih opasnosti u bolničkom liječenju diljem svijeta", naglasio je.





















